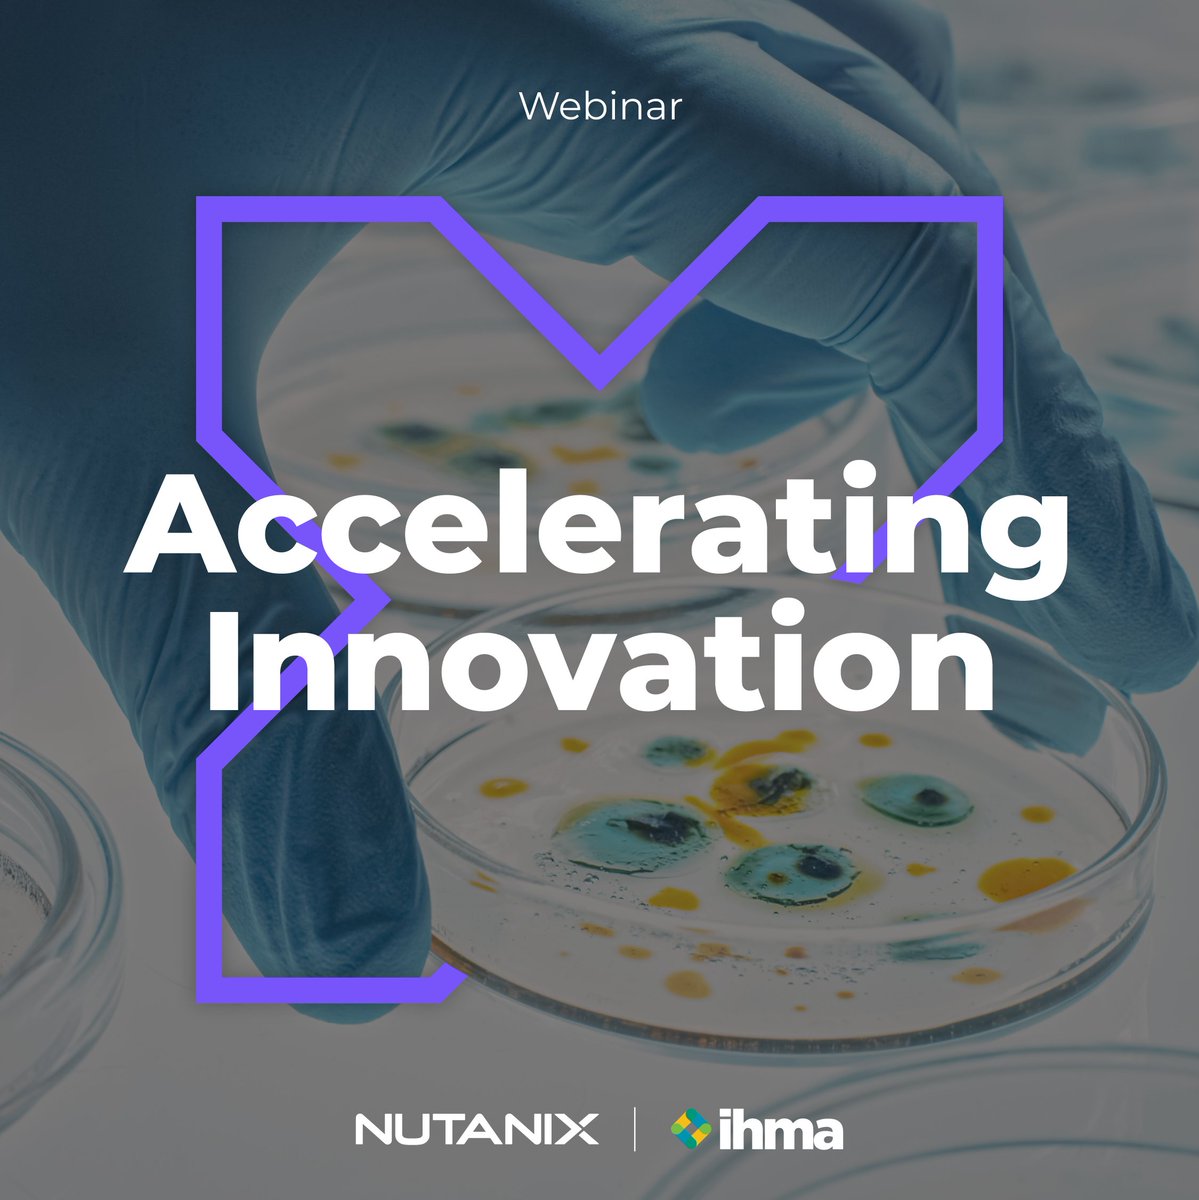

Nutanix Middle East
@nutanix_me
Nutanix delivers an Enterprise Hybrid Cloud that enables IT to focus on the applications and services that power their business with One OS, One Click.
ID: 881431122386800641
https://www.nutanix.com/ 02-07-2017 08:35:30
1,1K Tweet
4,4K Followers
239 Following





Shradha Subramanian, Nutanix Middle East, wins a Senior Marketing Leader of the Year Award, congratulations. #AccelerateAction #TahawultechWIT2025 #tahawultech


Shradha Subramanian, Nutanix Middle East, wins a Senior Marketing Leader of the Year Award, congratulations. #AccelerateAction #TahawultechWIT2025 #tahawultech















CMO Mandy Dhaliwal discusses 3 #NEXTconf announcements around Cloud Native AOS, the integration of NCI with Pure Storage FlashArray, & the latest version of NAI, which enables agentic AI anywhere through a deeper integration with @NVIDIA Enterpise AI: ntnx.com/4k5LBi2